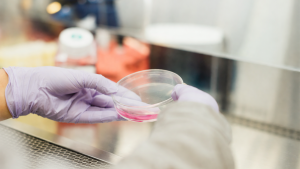
Image

Transforming decision-making in Africa
A world in which the use of timely evidence for urgent decisions reduces inequity and improves socioeconomic outcomes.

We are ACRES
Center for Rapid Evidence Synthesis (ACRES) is a knowledge brokering institution registered as an NGO based in Kampala, Uganda. ACRES builds on 16 years experience supporting policy makers with evidence at regional, national and sub-national levels in a timely manner. We partner with leaders across interconnected sectors vital to Uganda’s future: public health, education, Women Economic Empowerment, and the green transition—powering this work with cutting-edge AI and digital tools.
We take an evidence backed approach to decision-making
ACRES recognizes that enhancing the delivery of evidence-informed decision-making (EIDM) in Uganda requires continuous research, innovation, and evaluation to identify new and improved pathways and strategies
ACRES engages with policy networks to enhance the implementation of evidence-informed decision-making.ACRES assesses and analyses policy landscapes to identify opportunities for improvement.
ACRES is dedicated to building and sustaining the capacity of researchers, knowledge brokers, and decision-makers in evidence-informed decision-making (EIDM).
Through studies and operational research, ACRES explores new pathways and strategies for EIDM, seeking to improve its effectiveness and efficiency.
To Provide timely and responsive knowledge for equitable policy making. Our Goals are:
To facilitate access to timely, relevant and high-quality evidence in response to decision makers’ urgent needs and demands for policy and decision making
To research, evaluate and innovate pathways and strategies for evidence-informed decision-making to increase the effectiveness and efficiency of their delivery globally.
Programmes that we focus on to impact decision-making
News & Blogs

Evidence to Policy Training Programme graduates inaugural cohort
The first cohort of the Evidence to Policy Training Programme – Entry level celebrate the
completion of 15-weeks of study

DESTINY project to revolutionize climate action with AI-powered research
Floods cut off roads and homes in Kampala, Uganda Center for Rapid Evidence Synthesis (ACRES) announces the commencement of the DESTINY project, an international research

Insights from the Digital Gender Inclusive Tools for Evidence Use (DG – Tools) meeting
Partners in the implementation of the DG Tools project pose for a group photo following a meeting in Kampala The Digital Gender Inclusive Tools